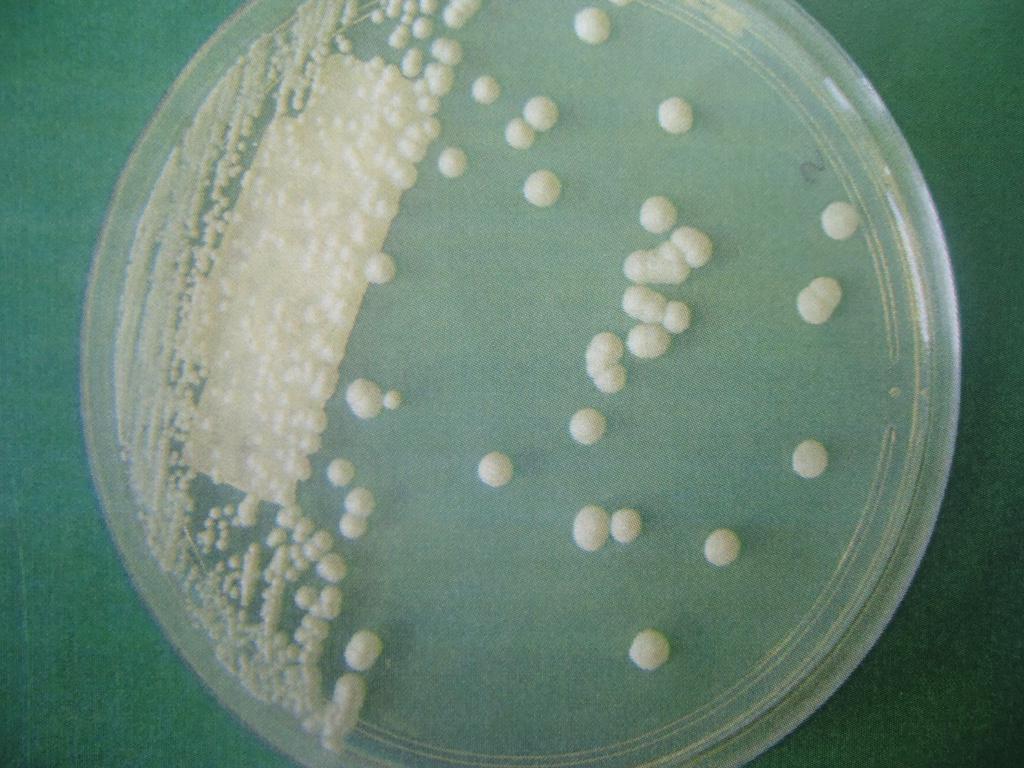
Infecções Fúngicas

Dr. Michel Laks, Infectologista
Graduei-me pela Escola Paulista de Medicina da Universidade Federal de São Paulo (EPM/Unifesp) em 2004, onde também concluí minha residência em Infectologia em 2008. Obtive o título de especialista em Infectologia pela Sociedade Brasileira de Infectologia em 2009. Completei meu mestrado pela EPM/Unifesp em 2016 e meu doutorado pela mesma instituição em 2024. Atuo principalmente nos temas de Infectologia e Educação em Saúde, oferecendo cuidados especializados e orientações preventivas para meus pacientes.